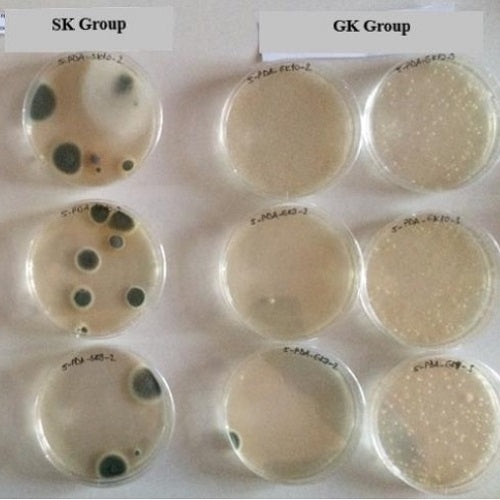

Yemoos Blog

Fermentation Jokes
July 03, 2025
The world is a little bit crazy right now, so sit back and enjoy some fermentation jokes! If you don't like fermentation jokes, miso sorry ;)

Instant Probiotics: The Benefits of Using a Freeze‑Dried Kefir Starter
April 18, 2025
A freeze‑dried milk kefir starter is simply the finished kefir that's filled with all the healthy bacteria and yeast.
The freeze drying process is intensive and expensive, but it's the most gentle process available to preserve the good stuff in kefir. Multiple studies show 95–98 % of probiotic cells make it through the process.

The risk of drinking raw milk (kefir) amid Bird Flu concerns
January 30, 2025
We have had several people contact us concerned about the bird flu virus (H5N1) and raw milk. There seem to be many articles and media outlets warning people about the dangers of drinking raw milk right now due to the possible viral contamination of raw milk. In modern-day society, raw milk tends to be the villain, so this kind of media frenzy is not exactly new to the 14 million (or more) Americans who drink raw milk every day. Is raw milk kefir safe? Let’s take an honest look at what's going on and the real risks involved.

The wonderful benefits of Paraprobiotics
February 11, 2023

9 Ways to Grow Milk Kefir Grains faster
June 11, 2022 5 Comments

The best milk kefir ratio – Scientifically proven
March 26, 2022 3 Comments

Why you should ripen your kefir
December 05, 2021 1 Comment

Kefir VS Coronavirus (COVID-19)
March 09, 2020 3 Comments

What is the optimal ratio of milk kefir grains to milk?
March 04, 2020 7 Comments
There is a great difference of opinion on what is the ideal ratio of grains to milk. On the one hand, growth and total probiotic count seem to increase with more grains per milk. However, you may be sacrificing flavor, texture, diversity and health of the grains with too many grains per milk.

Cold or Room Temp Milk for Making Kefir?
February 04, 2020 2 Comments
New study compares real kefir to a starter culture
January 17, 2020 2 Comments

Is stirring or shaking milk kefir beneficial?
January 04, 2020 2 Comments